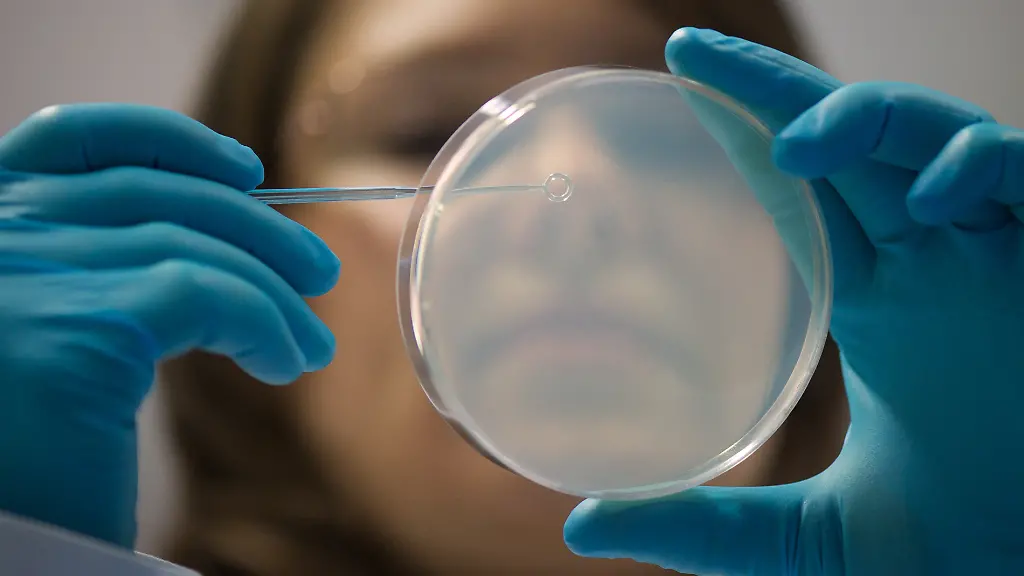
47738773

Deutsche BiotechbrancheAufschwung durch Corona-Pandemie beendet
In der deutschen Biotechbranche ist der Schwung durch die Corona-Pandemie abgeebbt. "Der Hype ist vorüber, die Finanzierungssituation wieder kritisch", erklärte Klaus Ort, Life-Science-Experte und Partner bei der Beratungsfirma EY, am Donnerstag bei der Vorstellung des deutschen Biotechnologie-Reports. Dennoch stehe die Branche gesünder da als je zuvor mit hoher Innovationskraft.
"Aber wir können deutlich mehr daraus machen." Die Finanzierung bleibe dabei einer der entscheidenden Herausforderungen. Es sei daher nötig, große Investoren wie deutsche Versicherungen sowie Renten- und Pensionsfonds zu mobilisieren, um Innovationen auch in Zukunft zu sichern.
Im vergangenen Jahr sank die Kapitalaufnahme in der deutschen Biotechbranche um 67 Prozent auf 812 Millionen Euro, nachdem im ersten Coronajahr 2020 noch drei Milliarden Euro an deutsche Biotechfirmen flossen. Damit lag die Finanzierung wieder auf dem Niveau vor der Pandemie, da sich Investoren angesichts der weltweiten Krisen, steigender Zinsen und schwacher Aktienkurse zurückhielten. Zugleich trieben einige Mega-Deals zwischen Biotechunternehmen und Pharmakonzernen das Volumen der Allianzen auf einen Rekordwert von mehr als 14 Milliarden Euro. Denn Pharmaunternehmen setzten verstärkt auf Partnerschaften statt auf riskante Übernahmen, um sich Nachschub an neuen Medikamenten zu sichern.